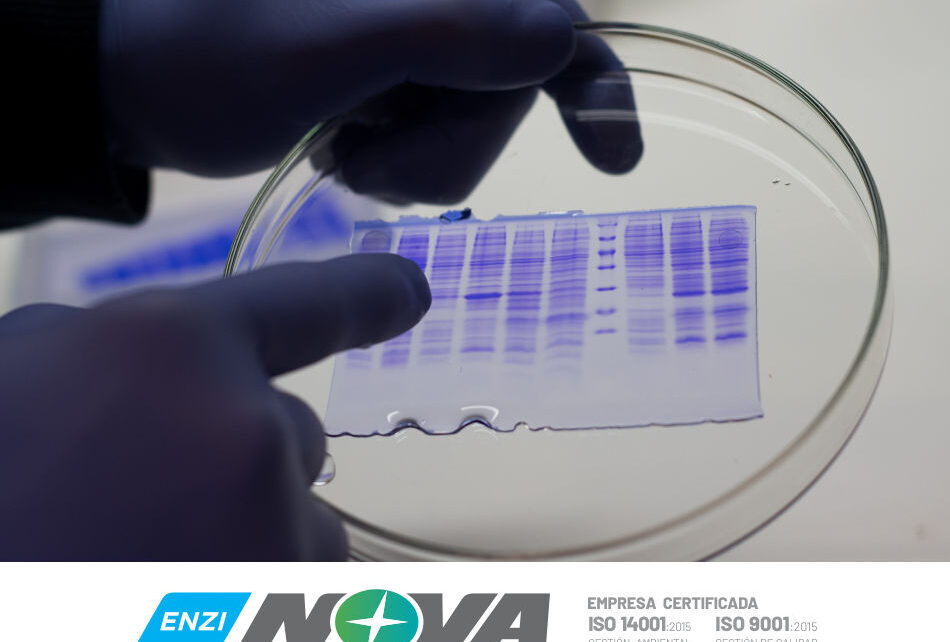

Una empresa dedicada a la biotecnología de Cañada de Gómez informó que el departamento de enzimas «logró producir en el laboratorio el desarrollo de proteínas con potencial efecto antiviral contra COVID-19». En la actualidad, informaron los responsables, se encuentran enfocados en prurificar estas proteínas y establecer alianzas colectivas con instituciones para probar la vacuna.
La empresa cañadense NOVA informó desde su portal laboratorios-nova.com/web/ que «dio el primer paso en el desarrollo de proteínas con potencial efecto antiviral contra COVID-19, al lograr producirlas en nuestro laboratorio». Y sostuvo que «esta línea de trabajo se encuentra aún en etapa de desarrollo inicial, por lo cual consideramos prudente –dada la relevancia del tema- ser lo más claros y abiertos posible para que la comunidad en su totalidad esté al tanto del desarrollo de nuestro trabajo».
Se trata de un equipo conformado por siete biotecnólogos y un ingeniero químico egresados de cinco Universidades Nacionales diferentes, varios con formación doctoral en el sistema científico argentino.
Y sostuvo que «en este momento, estamos enfocados en purificar estas proteínas, y estableciendo alianzas colaborativas con instituciones que se especialicen en la evaluación de la capacidad antiviral de las mismas. Es importante recalcar que en nuestras instalaciones no trabajamos con virus».
Nova opera en el mercado agropecuario desde hace 35 años, con origen en Cañada de Gómez. Sus tareas específicas son «formular, desarrollar y comercializar las principales líneas de productos para la protección y el crecimiento de los cultivos, haciendo de la investigación y el desarrollo sus puntos más fuertes».
Sin embargo, desde hace 8 años, trabaja en una nueva división «dedicada a la producción de enzimas, compuestos biológicos utilizados en diversas industrias: alimentaria, textil, farmacéutica y de biocombustibles».